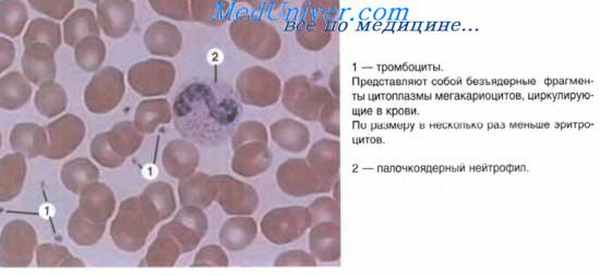
тромбоцитопоэз

Тромбоцитопоэз. Моноцитопоэз. Лимфоцитопоэз и иммуноцитопоэз.
Добавил пользователь Дмитрий К. Обновлено: 23.12.2025
Кроветворение (гемоцитопоэз) – процесс образования форменных элементов крови.
Различают два вида кроветворения:
В свою очередь миелоидное кроветворение подразделяется на:
Лимфоидное кроветворение подразделяется на:
Кроме того, гемопоэз подразделяется на два периода:
Эмбриональный период приводит к образованию крови как ткани и потому представляет собой гистогенез крови. Постэмбриональный гемопоэз представляет процесс физиологической регенерации крови как ткани.
Эмбриональный период гемопоэза
Он осуществляется в эмбриогенезе поэтапно, сменяя разные органы кроветворения. В соответствии с этим выделяют три этапа:
1. Желточный этап осуществляется в мезенхиме желточного мешка начиная со 2–3-й недели эмбриогенеза, с 4-й – снижается и к концу 3-го месяца полностью прекращается.
Вначале в желточном мешке в результате пролиферации мезенхимальных клеток образуются так называемые кровяные островки, представляющие собой очаговые скопления отростчатых клеток.
Наиболее важными моментами желточного этапа являются:
1) образование стволовых клеток крови;
2) образование первичных кровеносных сосудов.
Несколько позже (на 3-й неделе) начинают формироваться сосуды в мезенхиме тела зародыша, однако они являются пустыми щелевидными образованиями. Довольно скоро сосуды желточного мешка соединяются с сосудами тела зародыша, и устанавливается желточный круг кровообращения. Из желточного мешка по этим сосудам стволовые клетки мигрируют в тело зародыша и заселяют закладки будущих кроветворных органов (в первую очередь печень), в которых затем и осуществляется кроветворение.
3. Медуллотимусолимфоидный этап кроветворения. Закладка красного костного мозга начинается со 2-го месяца, кроветворение в нем начинается с 4-го месяца, а с 6-го месяца он является основным органом миелоидного и частично лимфоидного кроветворения, т. е. является универсальным кроветворным органом. В это же время в тимусе, селезенке и в лимфатических узлах осуществляется лимфоидное кроветворение.
В результате последовательной смены органов кроветворения и совершенствования процесса кроветворения формируется кровь как ткань, которая у новорожденных имеет существенные отличия от крови взрослых людей.
Постэмбриональный период кроветворения
Осуществляется в красном костном мозге и лимфоидных органах (тимусе, селезенке, лимфоузлах, миндалинах, лимфоидных фолликулах).
Сущность процесса кроветворения заключается в пролиферации и поэтапной дифференцировке стволовых клеток в зрелые форменные элементы крови.
В схеме кроветворения представлены два ряда кроветворения:
Каждый вид кроветворения подразделяется на разновидности (или ряды) кроветворения.
1) эритроцитопоэз (или эритроцитарный ряд);
2) гранулоцитопоэз (или грануляцитарный ряд);
3) моноцитопоэз (или моноцитарный ряд);
4) тромбоцитопоэз (или тромбоцитарный ряд).
1) Т-лимфоцитопоэз (или Т-лимфоцитарный ряд;
В процессе поэтапной дифференцировки стволовых клеток в зрелые форменные элементы крови в каждом ряду кроветворения образуются промежуточные типы клеток, которые в схеме кроветворения составляют классы клеток.
Всего в схеме кроветворения различают шесть классов клеток.
I класс – стволовые клетки. По морфологии клетки этого класса соответствуют малому лимфоциту. Эти клетки являются полипотентными, т. е. способны дифференцироваться в любой форменный элемент крови. Направление дифференцировки зависит от содержания форменных элементов в крови, а также от влияния микроокружения стволовых клеток – индуктивных влияний стромальных клеток костного мозга или другого кроветворного органа. Поддержание популяции стволовых клеток осуществляется следующим образом. После митоза стволовой клетки образуются две: одна вступает на путь дифференцировки до форменного элемента крови, а другая принимает морфологию лимфоцита малого размера, остается в костном мозге, является стволовой. Деление стволовых клеток происходит очень редко, их интерфаза составляет 1–2 года, при этом 80 % стволовых клеток находятся в состоянии покоя и только 20 % – в митозе и последующей дифференцировке. Стволовые клетки также получили название колинеобразующие единицы, так как каждая стволовая клетка дает группу (или клон) клеток.
II класс – полустволовые клетки. Эти клетки являются ограниченно полипотентными. Выделяют две группы клеток – предшественницы миелопоэза и лимфопоэза. По морфологии похожи на малый лимфоцит. Каждая из этих клеток дает клон миелоидного или лимфоидного ряда. Деление происходит раз в 3–4 недели. Поддержание популяции осуществляется аналогично полипотентным клеткам: одна клетка после митоза вступает в дальнейшую дифференцировку, а вторая остается полустволовой.
III класс – унипотентные клетки. Данный класс клеток является поэтинчувствительными – предшественниками своего ряда кроветворения. По морфологии они также соответствуют малому лимфоциту и способны к дифференцировке только в один форменный элемент крови. Частота деления данных клеток зависит от содержания в крови поэтина – биологически активного вещества, специфического для каждого ряда кроветворения, – эритропоэтина, тромбоцитопоэтина. После митоза клеток данного класса одна клетка вступает в дальнейшую дифференцировку до форменного элемента, а вторая поддерживает популяцию клеток.
Клетки первых трех классов объединяются в класс морфологически не идентифицируемых клеток, так как все они по морфологии напоминают малый лимфоцит, однако способности их к развитию различны.
IV класс – бластные клетки. Клетки этого класса отличаются по морфологии от всех остальных. Они крупные, имеют крупное рыхлое ядро (эухроматин) с 2–4 ядрышками, цитоплазма базофильна за счет большого количества свободных рибосом. Эти клетки часто делятся, и все дочерние вступают в дальнейшую дифференцировку. Бласты различных рядов кроветворения можно идентифицировать по цитохимическим свойствам.
V класс – созревающие клетки. Этот класс характерен для своего ряда кроветворения. В этом классе может быть несколько разновидностей переходных клеток от одной (пролимфоцит, промоноцит) до пяти в эритроцитарном ряду. Некоторые созревающие клетки в небольшом количестве могут попадать в периферический кровоток, например ретикулоциты или палочкоядерные лейкоциты.
VI класс – зрелые форменные элементы. К этому классы относятся эритроциты, тромбоциты и сегментоядерные гранулоциты. Моноциты не являются окончательно дифференцированными клетками. Они затем покидают кровеносное русло и дифференцируются в конечный класс – макрофаги. Лимфоциты дифференцируются в конечный класс при встрече с антигенами, при этом они превращаются в бласты и снова делятся.
Совокупность клеток, составляющих линию дифференцировки стволовой клетки в определенный форменный элемент, образует дифферон (или гистогенетический ряд). Например, эритроцитарный дифферон составляют:
1) стволовая клетка (I класс);
2) полустволовая клетка – предшественница миелопоэза (II класс);
3) унипотентная эритропоэтинчувствительная клетка (III класс);
4) эритробласт (IV класс);
5) созревающая клетка – пронормоцит, базофильный нормоцит, полихроматофильный нормоцит, оксифильный нормоцит, ретикулоцит (V класс);
6) эритроцит (VI класс).
В процессе созревания эритроцитов в V классе происходят синтез и накопление гемоглобина, редукция органелл и клеточного ядра. В норме пополнение эритроцитов осуществляется за счет деления и дифференцировки созревающих клеток – пронормоцитов, базофильных и полихроматофильных нормоцитов. Такой тип кроветворения получил название гомопластического. При выраженной кровопотере пополнение эритроцитов осуществляется не только усилением созревающих клеток, но и клеток IV, III, II и даже I класса – происходит гетеропластический тип кроветворения.
Гранулопоэз
Образование гранулоцитов происходит в миелоидной ткани красного костного мозга. Исходная стволовая клетка превращается в мультипотентную клетку — предшественник миело-поэза (КОЕ-ГЭММ) и далее под воздействием колониестимулирующих факторов дифференцируется в общую родоначальную клетку для гранулоцитов и моноцитов (КОЕ-ГМн). В дальнейшем в результате дивергенции возникают родоначальные клетки для гранулоцитов (КОЕ-Гн), которые дифференцируются в идентифицируемые миелобласты (V класс клеток). В ряду дальнейшей клеточной дифференцировки (V класс клеток) различают стадии: промиелоцита, миелоцита, метамиелоцита. Начиная со стадии промиелоцита, клетки подразделяются на 3 разновидности: нейтрофильные, эозинофильные, базофильные. Более отчетливо это подразделение можно провести на стадии миелоцитов, когда в клетках накапливается достаточное количество специфической зернистости. До стадии миелоцитов включительно клетки гранулоцитопоэза делятся митозом. Метамиелоциты митозом уже не делятся. В этих клетках ядро приобретает вначале палочковидную, а затем сегментированную форму.
Общее направление дифференцировки клеток гранулопоэза характеризуется: постепенным уменьшением размеров клетки, снижением базофилии цитоплазмы, появлением в цитоплазме специфических гранул, уменьшением размеров ядра, появлением сегментированности ядра и его уплотнением, сдвигом ядерно-цитоплазменного отношения в сторону преобладания размеров цитоплазмы над размерами ядра.
В периферическую кровь поступают зрелые гранулоциты (VI класс клеток) — нейтрофилы, эозинофилы и базофилы, а также небольшое количество малодифференцированных (юных) гранулоцитов. Физиологическая регенерация обеспечивается делением преимущественно клеток V класса — миелоцитов.
Тромбоцитопоэз
Мультипотентные клетки (КОЕ-ГЭММ) миелопоэза под влиянием факторов микроокружения и тромбопоэтина дифференцируются в родоначальные клетки мегакариоцитарного ряда (КОЕ-Мег). Далее этот ряд включает следующие формы: мега-кариобласт, промегакариоцит, мегакариоцит, тромбоциты.
Мегакариобласт — крупная полиплоидная клетка. По мере увеличения степени плоидности до 32—64 п она приобретает гигантские размеры. Наиболее дифференцированная клетка этого ряда — мегакариоцит — имеет базофильную цитоплазму с многочисленными азурофильными гранулами. Происходит значительное увеличение размеров ядра вследствие его полиплоидизации и сегментации. Мегакариоциты находятся в миелоидной ткани красного костного мозга. От поверхности цитоплазмы этих клеток по каналам агранулярной эндоплазматической сети отшнуровываются небольшие фрагменты, превращающиеся в кровяные пластинки. Последние попадают в кровяное русло. Основное проявление дифференцировки клеток при тромбоцитопоэзе сводится к увеличению размеров мегакариобластов, полиплоидизации, появлению в цитоплазме азурофильной зернистости, отшнуровыванию фрагментов цитоплазмы путем образования впячиваний плазмолеммы, отделению от мегакариоцитов кровяных пластинок, попадающих в кровь.
Моноцитопоэз
Моноцитопоэз — образование моноцитов — происходит в красном костном мозге из стволовых клеток через стадии КОЕ-ГЭММ, далее — КОЕ-ГМо, затем КОЕ-Мо, монобласта, промоноцита и моноцита. Конечной стадией дифференцировки клеток моноцитарного ряда является не моноцит, а макрофаг (мононуклеарный фагоцит), который находится вне сосудистого русла. Дифференцировка клеток при моноцитопоэзе характеризуется увеличением размеров клетки, приобретением ядра бобовидной формы, снижением базофилии цитоплазмы, превращением моноцита в макрофаг.
Лимфоцитопоэз и иммуноцитопоэз
Лимфоидная ткань у человека имеется в составе лимфатических узлов, селезенки, миндалин, аппендикса и в других лимфоидных образованиях по ходу пищеварительного тракта. В лимфоидной ткани происходит лимфопоэз. Исходными клетками лимфопоэза являются стволовые клетки красного костного мозга. Через стадию мультипотентных клеток (КОЕ-Л) они дифференцируются в родоначальные про-Т- и про-В-лимфобласты и далее в Т- и В-лимфобласты, Т- и В-пролимфоциты и Т-и В-лимфоциты.
В лимфоцитопоэзе в тимусе возникают субпопуляции Т-клеток с различными рецепторами (так называемая антиген-независимая пролиферация и дифференцировка). Т-лимфоциты участвуют в формировании клеточного иммунитета. Другой ряд дифференцировки в лимфопоэзе приводит к образованию из В-лимфоцитов через стадии плазмобласта и проплазмоцита плазматических клеток (плазмоцитов). Эти клетки вырабатывают антитела, обеспечивая гуморальный иммунитет. Подробнее образование иммунокомпетентных клеток и их участие в развитии воспаления рассматриваются ниже.
Из лимфобластов образуются большие, средние и малые лимфоциты. Этот ряд дифференцировки сопровождается уменьшением размеров клеток, уплотнением ядер, снижением митотической активности. Малые лимфоциты способны к «бласттрансформации» — своеобразной дедифференцировке с последующей повторной их дифференцировкой. Явление бласттрансформации открыто А. А. Максимовым (1902).
Тромбоцитопоэз. Моноцитопоэз. Лимфоцитопоэз и иммуноцитопоэз.
Тромбоцитопоэз. Моноцитопоэз. Лимфоцитопоэз и иммуноцитопоэз.
Мультипотентные клетки (КОЕ-ГЭММ) миелопоэза под влиянием факторов микроокружения и тромбопоэтина дифференцируются в родоначальные клетки мегакариоцитарного ряда (КОЕ-Мег). Далее этот ряд включает следующие формы: мегакариобласт, промегакариоцит, мегакариоцит, тромбоциты.
Мегакариобласт — крупная полиплоидная клетка. По мере увеличения степени плоидности до 32-64 п она приобретает гигантские размеры. Наиболее дифференцированная клетка этого ряда — мегакариоцит — имеет базофильную цитоплазму с многочисленными азурофильными гранулами. Происходит значительное увеличение размеров ядра вследствие его полиплоидизации и сегментации. Мегакариоциты находятся в миелоидной ткани красного костного мозга. От поверхности цитоплазмы этих клеток по каналам агранулярной эндоплазматической сети отшнуровываются небольшие фрагменты, превращающиеся в кровяные пластинки. Последние попадают в кровяное русло. Основное проявление дифференцировки клеток при тромбоцитопоэзе сводится к увеличению размеров мегакариобластов, полиплоидизации, появлению в цитоплазме азурофильной зернистости, отшнуровыванию фрагментов цитоплазмы путем образования впячиваний плазмолеммы, отделению от мегакариоцитов кровяных пластинок, попадающих в кровь.
Моноцитопоэз. Моноцитопоэз — образование моноцитов — происходит в красном костном мозге из стволовых клеток через стадии КОЕ-ГЭММ, далее — КОЕ-ГМо, затем КОЕ-Мо, монобласта, промоноцита и моноцита. Конечной стадией дифференцировки клеток моноцитарного ряда является не моноцит, а макрофаг (мононуклеарный фагоцит), который находится вне сосудистого русла. Дифференцировка клеток при моноцитопоэзе характеризуется: увеличением размеров клетки, приобретением ядра бобовидной формы, снижением базофилии цитоплазмы, превращением моноцита в макрофаг.
Лимфоцитопоэз и иммуноцитопоэз. Лимфоидная ткань у человека имеется в составе лимфатических узлов, селезенки, миндалин, аппендикса и в других лимфоидных образованиях по ходу пищеварительного тракта. В лимфоидной ткани происходит лимфопоэз. Исходными клетками лимфопоэза являются стволовые клетки красного костного мозга. Через стадию мультипотентных клеток (КОЕ-Л) они дифференцируются в родоначальные про-Т- и про-В-лимфобласты и далее в Т- и В-лимфобласты, Т- и В-пролимфоциты и Т- и В-лимфоциты.
В лимфоцитопоэзе в тимусе возникают субпопуляции Т-клеток с различными рецепторами (так называемая антигеннезависимая пролиферация и дифференцировка). Т-лимфоциты участвуют в формировании клеточного иммунитета. Другой ряд дифференцировки в лимфопоэзе приводит к образованию из В-лимфоцитов через стадии плазмобласта и проплазмоцита — плазматических клеток (плазмоцитов). Эти клетки вырабатывают антитела, обеспечивая гуморальный иммунитет. Подробнее образование иммунокомпетентных клеток и их участие в развитии воспаления рассматриваются ниже.
Из лимфобластов образуются большие, средние и малые лимфоциты. Этот ряд дифференцировки сопровождается уменьшением размеров клеток, уплотнением ядер, снижением митотической активности. Малые лимфоциты способны к "бласттрансформации" — своеобразной дедифференцировке с последующей повторной их дифференцировкой. Явление бласттрансформации открыто А.А. Максимовым (1902).
Информация на сайте подлежит консультации лечащим врачом и не заменяет очной консультации с ним.
См. подробнее в пользовательском соглашении.
постэмбр
Введение Кроветворением, или гемопоэзом, называют развитие крови. Различают эмбриональный гемопоэз, который происходит в эмбриональный период и приводит к развитию крови как ткани, и постэмбриональныйгемопоэз, который представляет собой процесс физиологической регенерации крови. Развитие эритроцитов называют эритропоэзом, развитие гранулоцитов — гранулоцитопоэзом, тромбоцитов — тромбоцитопоэзом, моноцитов — моноцитопоэзом, развитие лимфоцитов и иммуноцитов — лимфоцито- и иммуноцитопоэзом.
Постэмбриональный период кроветворения
Осуществляется в красном костном мозге и лимфоидных органах (тимусе, селезенке, лимфоузлах, миндалинах, лимфоидных фолликулах).
Сущность процесса кроветворения заключается в пролиферации и поэтапной дифференцировке стволовых клеток в зрелые форменные элементы крови.
В схеме кроветворения представлены два ряда кроветворения:
Каждый вид кроветворения подразделяется на разновидности (или ряды) кроветворения.
1) эритроцитопоэз (или эритроцитарный ряд);
2) гранулоцитопоэз (или грануляцитарный ряд);
3) моноцитопоэз (или моноцитарный ряд);
4) тромбоцитопоэз (или тромбоцитарный ряд).
1) Т-лимфоцитопоэз (или Т-лимфоцитарный ряд;
В процессе поэтапной дифференцировки стволовых клеток в зрелые форменные элементы крови в каждом ряду кроветворения образуются промежуточные типы клеток, которые в схеме кроветворения составляют классы клеток.
Всего в схеме кроветворения различают шесть классов клеток.
I класс – стволовые клетки. По морфологии клетки этого класса соответствуют малому лимфоциту. Эти клетки являются полипотентными, т. е. способны дифференцироваться в любой форменный элемент крови. Направление дифференцировки зависит от содержания форменных элементов в крови, а также от влияния микроокружения стволовых клеток – индуктивных влияний стромальных клеток костного мозга или другого кроветворного органа. Поддержание популяции стволовых клеток осуществляется следующим образом. После митоза стволовой клетки образуются две: одна вступает на путь дифференцировки до форменного элемента крови, а другая принимает морфологию лимфоцита малого размера, остается в костном мозге, является стволовой. Деление стволовых клеток происходит очень редко, их интерфаза составляет 1 – 2 года, при этом 80% стволовых клеток находятся в состоянии покоя и только 20% – в митозе и последующей дифференцировке. Стволовые клетки также получили название колинеобразующие единицы, так как каждая стволовая клетка дает группу (или клон) клеток.
II класс – полустволовые клетки. Эти клетки являются ограниченно полипотентными. Выделяют две группы клеток – предшественницы миелопоэза и лимфопоэза. По морфологии похожи на малый лимфоцит. Каждая из этих клеток дает клон миелоидного или лимфоидного ряда. Деление происходит раз в 3 – 4 недели. Поддержание популяции осуществляется аналогично полипотентным клеткам: одна клетка после митоза вступает в дальнейшую дифференцировку, а вторая остается полустволовой.
III класс – унипотентные клетки. Данный класс клеток является поэтинчувствительными – предшественниками своего ряда кроветворения. По морфологии они также соответствуют малому лимфоциту и способны к дифференцировке только в один форменный элемент крови. Частота деления данных клеток зависит от содержания в крови поэтина – биологически активного вещества, специфического для каждого ряда кроветворения, – эритропоэтина, тромбоцитопоэтина. После митоза клеток данного класса одна клетка вступает в дальнейшую дифференцировку до форменного элемента, а вторая поддерживает популяцию клеток.
Клетки первых трех классов объединяются в класс морфологически не идентифицируемых клеток, так как все они по морфологии напоминают малый лимфоцит, однако способности их к развитию различны.
IV класс – бластные клетки. Клетки этого класса отличаются по морфологии от всех остальных. Они крупные, имеют крупное рыхлое ядро (эухроматин) с 2 – 4 ядрышками, цитоплазма базофильна за счет большого количества свободных рибосом. Эти клетки часто делятся, и все дочерние вступают в дальнейшую дифференцировку. Бласты различных рядов кроветворения можно идентифицировать по цитохимическим свойствам.
V класс – созревающие клетки. Этот класс характерен для своего ряда кроветворения. В этом классе может быть несколько разновидностей переходных клеток от одной (пролимфоцит, промоноцит) до пяти в эритроцитарном ряду. Некоторые созревающие клетки в небольшом количестве могут попадать в периферический кровоток, например ретикулоциты или палочкоядерные лейкоциты.
VI класс – зрелые форменные элементы. К этому классы относятся эритроциты, тромбоциты и сегментоядерные гранулоциты. Моноциты не являются окончательно дифференцированными клетками. Они затем покидают кровеносное русло и дифференцируются в конечный класс – макрофаги. Лимфоциты дифференцируются в конечный класс при встрече с антигенами, при этом они превращаются в бласты и снова делятся.
Совокупность клеток, составляющих линию дифференцировки стволовой клетки в определенный форменный элемент, образует дифферон (или гистогенетический ряд). Например, эритроцитарный дифферон составляют:
1) стволовая клетка (I класс);
2) полустволовая клетка – предшественница миелопоэза (II класс);
3) унипотентная эритропоэтинчувствительная клетка (III класс);
4) эритробласт (IV класс);
5) созревающая клетка – пронормоцит, базофильный нормоцит, полихроматофильный нормоцит, оксифильный нормоцит, ретикулоцит (V класс);
6) эритроцит (VI класс).
В процессе созревания эритроцитов в V классе происходят синтез и накопление гемоглобина, редукция органелл и клеточного ядра. В норме пополнение эритроцитов осуществляется за счет деления и дифференцировки созревающих клеток – пронормоцитов, базофильных и полихроматофильных нормоцитов. Такой тип кроветворения получил название гомопластического. При выраженной кровопотере пополнение эритроцитов осуществляется не только усилением созревающих клеток, но и клеток IV, III, II и даже I класса – происходит гетеропластический тип кроветворения.
Иммуноцитопоэз и участие иммунных клеток реакциях иммунитета
В отличие от миелопоэза лимфоцитопоэз в эмбриональном и постэмбриональном периодах осуществляется поэтапно, сменяя разные лимфоидные органы. Как отмечалось ранее, лимфоцитопоэз подразделяется на:
В свою очередь, они делятся на три этапа:
1) костномозговой этап;
2) этап антигеннезависимой дифференцировки, осуществляемый в центральных иммунных органах;
3) этап антигензависимой дифференцировки, осуществляемый в периферических лимфоидных органах.
Т-лимфоцитопоэз
Первый этап осуществляется в лимфоидной ткани красного костного мозга, где образуются следующие классы клеток:
1) стволовые клетки – I класс;
2) полустволовые клетки предшественники Т-лимфоцитопоэза – II класс;
3) унипотентные Т-поэтинчувствительные клетки, предшественницы Т-лимфоцитопоэза. Эти клетки мигрируют в кровяное русло и достигают вилочковой железы (тимуса) – III класс.
Второй этап – антигеннезависимая дифференцировка, которая осуществляется в корковом веществе тимуса. При этом происходит дальнейшее образование Т-лимфоцитов. Стромальными клетками выделяется тимозин, под влиянием которого происходит превращение унипотентных клеток в Т-лимфобласты. Они являются клетками IV класса в Т-лимфоцитопоэзе. Т-лимфобласты превращаются в Т-пролимфоциты (клетки V класса), а они в Т-лимфоциты – VI класс.
В тимусе из унипотентных клеток развиваются самостоятельно три субпопуляции Т-лимфоцитов – Т-киллеры, Т-хелперы, Т-супрессоры.
Образовавшиеся Т-лимфоциты приобретают в корковом веществе тимуса разные рецепторы к разнообразным антигенам, при этом сами антигены в тимус не поступают. Защита вилочковой железы от попадания чужеродных антигенов осуществляется за счет наличия гематотимусного барьера и отсутствия приносящих сосудов в тимусе.
В результате второго этапа образуются субпопуляции Т-лимфоцитов, которые обладают различными рецепторами к определенным антигенам. В тимусе также происходит образование Т-лимфоцитов, обладающих рецепторами к антигенам собственных тканей, однако такие клетки сразу же разрушаются макрофагами.
После образования Т-лимфоциты, не проникая в мозговое вещество тимуса, поступают в кровоток и заносятся в периферические лимфоидные органы.
Третий этап (антигеннезависимая дифференцировка) осуществляется в Т-зависимых зонах периферических лимфоидных органов – лимфатических узлах и селезенке. Здесь создаются условия для встречи антигена с Т-лимфоцитом (киллером, хелпером или супрессором), имеющим рецептор к данному антигену.
Чаще всего происходит не непосредственное взаимодействие Т-лимфоцита с антигеном, а опосредованное – через макрофаг. При поступлении в организм чужеродного антигена он вначале фагоцитируется макрофагом (завершенный фагоцитоз), частично расщепляется, а антигенная детерминанта выносится на поверхность макрофага, где концентрируется. Затем эти детерминанты передаются макрофагами на соответствующие рецепторы различных субпопуляций Т-лимфоцитов. Под влиянием специфического антигена происходит реакция бластотрансформации – превращение Т-лимфоцита в Т-лимфобласт. Дальнейшая дифференцировка клеток зависит от того, какая субпопуляция Т-лимфоцитов провзаимодействовала с антигеном.
Т-киллерный лимфобласт дает следующие клоны клеток.
1. Т-киллеры (или цитотоксические лимфоциты), являющиеся эффекторными клетками, обеспечивающими клеточный иммунитет. Т-киллеры обеспечивают первичный иммунный ответ – реакцию организма на первое взаимодействие с антигеном.
В процессе уничтожения киллерами чужеродного антигена можно выделить два основных механизма: контактное взаимодействие – разрушение участка цитолеммы клетки-мишени и дистантное взаимодействие – выделение цитотоксических факторов, действующих на клетку-мишень постепенно и длительно.
2. Клетки Т-памяти. Эти клетки при повторной встрече организма с тем же антигеном обеспечивают вторичный иммунный ответ, который сильнее и быстрее первичного.
Т-хелперный лимфобласт дает следующие клоны клеток:
1) Т-хелперы, секретирующие медиатор лимфокин, стимулирующий гуморальный иммунитет. Это индуктор иммунопоэза;
2) клетки Т-памяти.
Т-супрессорный лимфобласт дает следующие клоны клеток:
2) клетки Т-памяти.
Таким образом, в ходе третьего этапа Т-лимфоцитопоэза происходит образование эффекторных клеток каждой субпопуляции Т-лимфоцитов (Т-киллеров, Т-хелперов и Т-супрессоров), обладающих определенной функцией, и клеток Т-памяти, обеспечивающих вторичный иммунный ответ.
В клеточном иммунитете можно выделить два механизма уничтожение киллерами клеток-мишеней – контактное взаимодействие, при котором происходит разрушение участка цитолеммы клетки-мишени и ее гибель, и дистантное взаимодействие – выделение цитотоксических факторов, действующих на клетку-мишень постепенно и вызывающих ее гибель через определенное время.
В-лимфоцитопоэз
В процессе В-лимфоцитопоэза можно выделить следующие этапы.
Первый этап – осуществляется в красном костном мозге, где образуются следующие классы клеток:
1) стволовые клетки – I класс;
2) полустволовые клетки, предшественницы лимфопоэза – II класс;
3) унипотентные В-лимфопоэтинчувствительные клетки – предшественницы В-лимфоцитопоэза – III класс.
Второй этап – антигеннезависимая дифференцировка – у птиц осуществляется в специальном органе – фабрициевой сумке, у млекопитающих в том числе и у человек такой орган не найден. Большинство исследователей считает, что второй этап (так же как и первый) осуществляется в красном костном мозге, где образуются В-лимфобласты – клетки IV класса. Затем происходит их пролиферация в В-пролимфоциты – клетки V класса и в В-лимфоциты – клетки VI класса. В процессе второго этапа В-лимфоциты приобретает разнообразные рецепторы к антигенам. При этом установлено, что рецепторы представлены белками – иммуноглобулинами, которые синтезируются в самих же созревающих В-лимфоцитах, затем выносятся на поверхность и встраиваются в плазмолемму. Концевые химические группировки у этих рецепторов различны, и именно этим объясняется специфичность восприятия ими определенных антигенных детерминант разных антигенов.
Третий этап – антигензависимая дифференцировка осуществляется в В-зависимых зонах периферических лимфоидных органов – в селезенке и лимфатических узлах. Тут происходит встреча В-лимфоцитов с антигенами, их последующая активация и трансформация в иммунобласт. Это происходит только при участии дополнительных клеток – макрофагов, Т-хелперов и Т-супрессоров. Следовательно, для активации В-лимфоцитов необходима кооперация следующих клеток – В-лимфоцита, Т-хелпера или Т-супрессора, а также гуморального антигена – бактерии, вируса или белка полисахарида. Процесс взаимодействия протекает следующим образом: антигенпредставляющий макрофаг фагоцитирует антиген и выносит на поверхность клеточной мембраны антигенную детерминанту, после этого детерминанта воздействует на В-лимфоциты, Т-хелперы и Т-супрессоры. Таким образом, влияния антигенной детерминанты на В-лимфоцит недостаточно для реакции бластотрансформации, она протекает после активации Т-хелпера и выделения им активирующего лимфокина. После этого В-лимфоцит превращается в иммунобласт. После пролиферации иммунобласта образуются клоны клеток – плазмоциты – эффекторные клетки гуморального иммунитета, они синтезируют и выделяют в кровь иммуноглобулины – антитела различных классов и клетки В-памяти.
Иммуноглобулины (антитела) взаимодействуют со специфическими антигенами, образуется комплекс «антиген – антитело», таким образом происходит нейтрализация чужеродных антигенов.
Т-хелперы играют следующую функцию в осуществлении гуморального иммунитета – способствуют реакции бластотрансформации, заменяют синтез неспецифических иммуноглобулинов на специфические, стимулируют синтез и выделение иммуноглобулинов плазмоцитами.
Т-супрессоры активируются этими же антигенами и выделяют лимфокины, угнетающие образование плазмоцитов и синтез ими иммуноглобулинов вплоть до полного прекращения. Таким образом, воздействие на В-лимфоцит Т-киллеров и Т-хелперов регулирует реакции гуморального иммунитета.
Кроветворение:эритроцитоз , гранулоцитопоэз, тромбоцитопоэз, лимфо- и моноцитопоэз
Кроветворение, гемопоэз (от греч. háima — кровь и póiēsis — изготовление, сотворение), процесс образования, развития и созревания клеток крови у животных и человека. (Афанасьев Ю.И., Юрина Н.А., Котовский Е.Ф. Гистология, цитология и эмбриология.—М ., 2002).

Эритроцитопоэз начинается со стволовой кроветворной клетки. Через стадию колониеобразующей мультипотентной клетки (КОЕТЭММ)
формируются бурстобразующая (БОЭ-Э) и далее колониеобразующая единица эритроцитов (КОЕ-Э). Клетки этих колоний чувствительны к факторам регуляции пролиферации и дифференцировки. Например, эритропоэтин, вырабатываемый клетками почки, стимулирует пролиферацию и дифференцировку клеток в эритробласты.
В IV-й класс включаются базофильный, полихроматофильный и оксифильный эритробласты. Проэритроциты, потом ретикулоциты составляют V-й класс и, наконец, формируются эритроциты (VI-й класс). В эритропоэзе на стадии оксифильного эритробласта происходит выталкивание ядра. В целом цикл развития эритроцита до выхода ретикулоцита в кровь продолжается до 12 суток. Общее направление эритропоэза характеризуется следующими основными структурно-функциональными изменениями: постепенным уменьшением размеров клетки, накоплением в цитоплазме гемоглобина, редукцией органелл, снижением базофилии и повышением оксифилии цитоплазмы, уплотнением ядра с последующим его выделением из состава клетки. В эритробластических островках эритробласты поглощают путем микропиноцитоза железо, поставляемое макрофагами, для синтеза гемоглобина.
Развитие эритроцитов происходит в миелоидной ткани красного костного мозга. В периферическую кровь поступают только зрелые эритроциты и немного ретикулоцитов.
Состояние, при котором содержание гемоглобина в крови значительно снижено, называется анемией. Оно бывает связано либо с уменьшением числа эритроцитов, либо с понижением содержания гемоглобина в них, и возникает в результате ряда причин: генетических (например, серповидноклеточная анемия, связанная с нарушением синтеза гемоглобина и распадом эритроцитов), кровопотери, воздействия гемолитических ядов, вызывающих распад эритроцитов, дефицита железа или витамина B12. В норме потребность в эритроцитах обеспечивается за счет размножения клеток IV-V-ro классов. Этот процесс называется гомопластическим гемопоэзом. При резком дефиците эритроцитов, вызванном кровопотерей или другими факторами, гомопластического гемопоэза оказывается недостаточно. Эритроциты начинают развиваться путем деления клеток I-III-го классов. Такой процесс называется гетеропластическим гемопоэзом.
Гранулоцитопоэз .
Образование гранулоцитов происходит в миелоидной ткани красного костного мозга. Исходная стволовая клетка превращается в мультипотентную клетку — предшественник миелопоэза (КОЕ-ГЭММ) и далее под воздействием колониестимулирующих факторов дифференцируется в общую родоначальную клетку для гранулоцитов и моноцитов (КОЕ-ГМн). В дальнейшем в результате дивергенции возникают родоначальные клетки для гранулоцитов (КОЕ-Гн), которые дифференцируются в идентифицируемые миелобласты (IV-й класс клеток). В ряду дальнейшей клеточной дифференцировки (V-й класс клеток) различают стадии: промиелоцита, миелоцита, метамиелоцита. Начиная со стадии промиелоцита, клетки подразделяются на 3 разновидности: нейтрофильные, эозинофильные, базофильные. Более отчетливо это подразделение можно провести на стадии миелоцитов, когда в клетках накапливается достаточное количество специфической зернистости. До стадии миелоцитов включительно клетки гранулоцитопоэза делятся митозом. Метамиелоциты митозом уже не делятся. В этих клетках ядро приобретает вначале палочковидную, а затем сегментированную форму.
Общее направление дифференцировки клеток гранулопоэза характеризуется: постепенным уменьшением размеров клетки, снижением базофилии цитоплазмы, появлением в цитоплазме специфических гранул, уменьшением размеров ядра, появлением сегментированности ядра и его уплотнением, сдвигом ядерно-цитоплазменного отношения в сторону преобладания размеров цитоплазмы над размерами ядра.
В периферическую кровь поступают зрелые гранулоциты (VI-й класс клеток) — нейтрофилы, эозинофилы и базофилы, а также небольшое количество малодифференцированных (юных) гранулоцитов. Физиологическая регенерация обеспечивается делением преимущественно клеток V-ro класса — миелоцитов.

Моноцитопоэз. Моноцитопоэз — образование моноцитов — происходит в красном костном мозге из стволовых клеток через стадии КОЕ-ГЭММ, далее — КОЕ-ГМо, затем КОЕ-Мо, монобласта, промоноцита и моноцита. Конечной стадией дифференцировки клеток моноцитарного ряда является не моноцит, а макрофаг (мононуклеарный фагоцит), который находится вне сосудистого русла. Дифференцировка клеток при моноцитопоэзе характеризуется: увеличением размеров клетки, приобретением ядра бобовидной формы, снижением базофилии цитоплазмы, превращением моноцита в макрофаг.
Лимфоцитопоэз и иммуноцитопоэз. Лимфоидная ткань у человека имеется в составе лимфатических узлов, селезенки, миндалин, аппендикса и в других лимфоидных образованиях по ходу пищеварительного тракта. В лимфоидной ткани происходит лимфопоэз. Исходными клетками лимфопоэза являются стволовые клетки красного костного мозга. Через стадию мультипотентных клеток (КОЕ-Л) они дифференцируются в родоначальные про-Т- и про-В-лимфобласты и далее в Т- и В-лимфобласты, Т- и В-пролимфоциты и Т- и В-лимфоциты.
В лимфоцитопоэзе в тимусе возникают субпопуляции Т-клеток с различными рецепторами (так называемая антигеннезависимая пролиферация и дифференцировка). Т-лимфоциты участвуют в формировании клеточного иммунитета. Другой ряд дифференцировки в лимфопоэзе приводит к образованию из В-лимфоцитов через стадии плазмобласта и проплазмоцита — плазматических клеток (плазмоцитов). Эти клетки вырабатывают антитела, обеспечивая гуморальный иммунитет. Подробнее образование иммунокомпетентных клеток и их участие в развитии воспаления рассматриваются ниже.
Из лимфобластов образуются большие, средние и малые лимфоциты. Этот ряд дифференцировки сопровождается уменьшением размеров клеток, уплотнением ядер, снижением митотической активности. Малые лимфоциты способны к "бласттрансформации" — своеобразной дедифференцировке с последующей повторной их дифференцировкой. Явление бласттрансформации открыто А.А. Максимовым (1902).

Тромбоцитопоэз (образование тромбоцитов в организме)
Митоз и дифференциацию КОК-мег активирует гемопоэтический цитокин — тромбопоэтин (тромбоцитопоэтин) при взаимодействии с интерлейкином-3. Этот гуморальный фактор стимулирует также эндомитоз мегакариоцитов, он необходим для нормального созревания цитоплазмы мегакариоцита и формирования в ней тромбоцитов. Стимулируют образование тромбоцитопоэтина уменьшение мегакариоцитов и их предшественников в костном мозге, а также тромбоцитопения, вызванная усиленным использованием тромбоцитов при формировании тромба (воспаление, необратимая агрегация тромбоцитов). Активированные тромбоциты и селезенка выделяют в кровь гуморальный ингибитор пролиферации КОК-мег, а также немитотической стадии развития мегакариоцитов (эндомитоза) и созревания цитоплазмы мегакариоцитов. Это гликопротеин, массой 12—17 кДа. (Юрина И.А. Гистология/И.А.Юрина и А.И. Радостина//Учебник.—М.:Медицина, 1995 год,256с.)
Теории кроветворения
В настоящее время общепринятой является унитарная теория кроветворения, на основании которой разработана схема кроветворения (И. Л. Чертков и А. И. Воробьев, 1973 г.).
- унитарная теория (А. А. Максимов, 1909 г.) - все форменные элементы крови развиваются из единого предшественникастволовой клетки;
- дуалистическая теория предусматривает два источника кроветворения, для миелоидного и лимфоидного;
- полифилетическая теория предусматривает для каждого форменного элемента свой источник развития.
В процессе поэтапной дифференцировки стволовых клеток в зрелые форменные элементы крови в каждом ряду кроветворения образуются промежуточные типы клеток, которые в схеме кроветворения составляют классы клеток. Всего в схеме кроветворения различают 6 классов клеток:
1 класс - стволовые клетки;
2 класс - полустволовые клетки;
3 класс - унипотентные клетки;
4 класс - бластные клетки;
5 класс - созревающие клетки;
6 класс - зрелые форменные элементы.
Морфологическая и функциональная характеристика клеток различных классов схемы кроветворения.
1 класс - стволовая полипотентная клетка, способная к поддержанию своей популяции. По морфологии соответствует малому лимфоциту, является полипотентной, то есть способной дифференцироваться в любой форменный элемент крови. Направление дифференцировки стволовой клетки определяется уровнем содержания в крови данного форменного элемента, а также влиянием микроокружения стволовых клеток - индуктивным влиянием стромальных клеток костного мозга или другого кроветворного органа. Поддержание численности популяции стволовых клеток обеспечивается тем, что после митоза стволовой клетки одна из дочерних клеток становится на путь дифференцировки, а другая принимает морфологию малого лимфоцита и является стволовой. Делятся стволовые клетки редко (1 раз в полгода), 80 % стволовых клеток находятся в состоянии покоя и только 20 % в митозе и последующей дифференцировке. В процессе пролиферации каждая стволовая клетка образует группу или клон клеток и потому стволовые клетки в литературе нередко называются клон-образующие единицы - КОЕ.
2 класс - полустволовые, ограниченно полипотентные (или частично коммитированные) клетки - предшественницы миелопоэза и лимфопоэза. Имеют морфологию малого лимфоцита. Каждая из них дает клон клеток, но только миелоидных или лимфоидных. Делятся они чаще (через 3-4 недели) и также поддерживают численность своей популяции.
3 класс - унипотентные поэтин-чувствительные клетки - предшественницы своего ряда кроветворения. Морфология их также соответствует малому лимфоциту. Способны дифференцироваться только в один тип форменного элемента. Делятся часто, но потомки этих клеток одни вступают на путь дифференцировки, а другие сохраняют численность популяции данного класса. Частота деления этих клеток и способность дифференцироваться дальше зависит от содержания в крови особых биологически активных веществ - поэтинов, специфичных для каждого ряда кроветворения (эритропоэтины, тромбопоэтины и другие).
Первые три класса клеток объединяются в класс морфологически неидентифицируемых клеток, так как все они имеют морфологию малого лимфоцита, но потенции их к развитию различны.
4 класс - бластные (молодые) клетки или бласты (эритробласты, лимфобласты и так далее). Отличаются по морфологии как от трех предшествующих, так и последующих классов клеток. Эти клетки крупные, имеют крупное рыхлое (эухроматин) ядро с 2-4 ядрышками, цитоплазма базофильна за счет большого числа свободных рибосом. Часто делятся, но дочерние клетки все вступают на путь дальнейшей дифференцировки. По цитохимическим свойствам можно идентифицировать бласты разных рядов кроветворения.
5 класс - класс созревающих клеток, характерных для своего ряда кроветворения. В этом классе может быть несколько разновидностей переходных клеток - от одной (пролимфоцит, промоноцит), до пяти в эритроцитарном ряду. Некоторые созревающие клетки в небольшом количестве могут попадать в периферическую кровь (например, ретикулоциты, юные и палочкоядерные гранулоциты).
6 класс - зрелые форменные элементы крови. Однако следует отметить, что только эритроциты, тромбоциты и сегментоядерные гранулоциты являются зрелыми конечными дифференцированными клетками или их фрагментами. Моноцитыне окончательно дифференцированные клетки. Покидая кровеносное русло, они дифференцируются в конечные клетки - макрофаги. Лимфоциты при встрече с антигенами, превращаются в бласты и снова делятся.
Совокупность клеток, составляющих линию дифференцировки стволовой клетки в определенный форменный элемент, образуют его дифферон или гистологический ряд. Например, эритроцитарный дифферон составляет:
- стволовая клетка;
- полустволовая клеткапредшественница миелопоэза;
- унипотентная эритропоэтинчувствительная клетка;
- эритробласт;
- созревающие клетки - пронормоцит, базофильный нормоцит, полихроматофильный нормоцит, оксифильный нормоцит, ретикулоцит, эритроцит.
Стволовая кроветворная клетка (Схема гемопоэза)
Любая клетка, обладающая по меньшей мере двумя свойствами, а именно, способностью к самоподдержанию и способностью к дифференцировке (не важно, в одном или в нескольких направлениях) является стволовой клеткой любой обновляющейся ткани (кроветворная система, кожа, кишечник и др.). Стволовые клетки способны восстанавливать кроветворение у облученных животных (радиозащитное действие), длительно поддерживать кроветворение и образовывать колониеобразующие единицы селезенки (двенадцатидневные селезеночные колонии), дающие начало гранулоцитарным, моноцитарным, эритроидным, мегакариоцитарным и лимфоидным колониям.
Все клетки гемопоэтического происхождения образуются из примитивных. Стволовая кроветворная клеток (пСКК), локализованных в костном мозге и дающих начало клеткам четырех основных направлений дифференцировки:
- миелоидного ( гранулоциты и моноядерные фагоциты ) и
Дивергенция общего стволового элемента происходит на самом раннем этапе костномозговой дифференцировки.
Антигенпрезентирующие клетки в основном, но не исключительно, развиваются из миелоидных клеток-предшественников.
Клетки миелоидного и лимфоидного ряда наиболее важны для функционирования иммунной системы.
Лимфопоэтическая своловая клетка определяет две самостоятельные линии развития, приводящие к образованию Т-клеток и В-клеток .
Первая образующаяся из ГСК клетка-предшественник представляет собой колониеобразующуюся единицу (КОЕ) , которая определяет линии развития, приводящие к образованию гранулоцитов , эритроцитов , моноцитов и мегакариоцитов . Созревание этих клеток происходит под влиянием колониестимулирующих факторов (КСФ) и ряда интерлейкинов , в том числе ИЛ-1 , ИЛ-3 , ИЛ-4 , ИЛ-5 и ИЛ-6 . Все они играют важную роль в положительной регуляции (стимуляции) гемопоэза и продуцируются, главным образом, стромальными клетками костного мозга , но также и зрелыми формами дифференцированных миелоидных и лимфоидных клеток. Другие цитокины (например, ТРФ-бета ) могут осуществлять понижающую регуляцию (подавление) гемопоэза).
У всех клеток как лимфоидного, так и миелоидного ряда время жизни ограничено, и все они непрерывно образуются.
У млекопитающих в период внутриутробного развития ГСК присутствуют в желточном мешке, печени, селезенке и костном мозге . Во взрослом организме гемопоэтические стволовые клетки находятся в основном в костном мозге, где они в норме довольно редко делятся, производя новые стволовые клетки (самообновление). Животное можно спасти от последствий облучения в летальных дозах введением клеток костного мозга, которые заселяют его лимфоидную и миелоидную ткани.
Плюрипотентные стволовые клетки дают начало коммитированным клеткам-предшественницам, которые уже необратимо определились как предки кровяных клеток одного или нескольких типов. Полагают, что коммитированные клетки делятся быстро, но ограниченное число раз, при этом делятся они под воздействием факторов микроокружения: соседних клеток и растворимых или мембраносвязанных цитокинов. В конце такой серии делений клетки эти становятся терминально дифференцированными, обычно больше не делятся и погибают через несколько дней или недель.
Плюрипотентные стволовые клетки малочисленны, их трудно распознавать, и все еще неясно, как они выбирают свой путь среди разных вариантов развития. Программирование клеточных делений и выведение клеток на определенный путь дифференцировки ( коммитирование ), видимо, включают в себя и случайные события.
Стволовая клетка плюрипотентна, т.к. дает начало многим видам терминально дифференцированных клеток. Что касается клеток крови, то эксперименты показывают, что все классы клеток крови - и миелоидных и лимфоидных - происходят от общей гемопоэтической стволовой клетки.
Гемопоэтическая стволовая клетка развивается следующим образом. У эмбриона гемопоэз начинается в желточном мешке, но по мере развития эта функция переходит к печени плода и, наконец, к костному мозгу , где и продолжается в течение всей жизни. Гемопоэтическая стволовая клетка, дающая начало всем элементам крови, плюрипотентна и заселяет другие гемо- и лимфопоэтические органы и самовоспроизводится, превращаясь в новые стволовые клетки. Животное можно спасти от последствий облучения в летальных дозах введением клеток костного мозга, которые заселяют его лимфоидную и миелоидную ткани (Афанасьев Ю.И., Юрина Н.А., 2001).
Во взрослом организме гемопоэтические стволовые клетки находятся главным образом в костном мозге, где они в норме довольно редко делятся, производя новые стволовые клетки (самообновление).
Клетку-предшественницу, дающую в культуре клеток начало колонии эритроцитов, называют колониеобразующей единицей эритроидного ряда , или КОЕ-Э , и она дает начало зрелым эритроцитам после шести или даже меньшего числа циклов деления. КОЕ-Э еще не содержит гемоглобин . (Седов, А.А. «Гистология человека: конспект лекций для вузов»/А.А. Седов//М.:серия «Конспект лекций».—2007 год, 324с.)

Поперечные профили набережных и береговой полосы: На городских территориях берегоукрепление проектируют с учетом технических и экономических требований, но особое значение придают эстетическим.
Папиллярные узоры пальцев рук - маркер спортивных способностей: дерматоглифические признаки формируются на 3-5 месяце беременности, не изменяются в течение жизни.

© cyberpedia.su 2017-2020 - Не является автором материалов. Исключительное право сохранено за автором текста.
Если вы не хотите, чтобы данный материал был у нас на сайте, перейдите по ссылке: Нарушение авторских прав. Мы поможем в написании вашей работы!
Читайте также:
